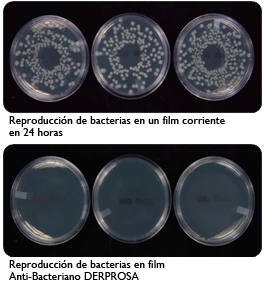

La variedad de films de Derprosa va desde el clásico film transparente hasta el más innovador film Anti-Bacteriano, el cual elimina el 99,9% de las bacterias que entren en contacto con él.
Derprosa, empresa especializada en la fabricación y comercialización de films de alta calidad, ofrece una amplia gama de films para el envasado y laminación en el sector de la alimentación. Estos films, además de ser parte del envoltorio o el envase, aportan un alto grado de seguridad, higiene y conservación a los alimentos o productos del hogar en cuyos envases son usados.
Los diferentes films de Derprosa empleados en el sector de la alimentación y el hogar se clasifican en dos categorías, en función de las propiedades que poseen: films estándar y films especiales.
Dentro de la primera categoría se engloban los films más tradicionales como el film transparente, cavitado perlado, mate y film con acabado blanco, utilizados generalmente en las bolsas y envoltorios de snacks y aperitivos, pan, tostadas y bollería, entre otros productos alimenticios y del hogar. Estos films proporcionan una excelente barrera al vapor de agua y son resistentes a aceites, grasas, ácidos y bases utilizados en la impresión, protegiendo al alimento de agentes externos.
La segunda categoría de films para alimentación que ofrece Derprosa, nace del compromiso de innovación e investigación de la compañía para mejorar sus productos y por ende los de sus clientes, consiguiendo films con propiedades diferenciadoras, como es el caso del film Anti-Bacteriano, fabricado con la misma calidad y acabados que los films estándar de Derprosa y con una exclusiva y revolucionaria solución para el sector de la alimentación, ya que elimina el 99,9% de las bacterias que entran en contacto con el film. Este film es idóneo para el envasado de frutas, verduras, hortalizas y congelados.

Otros films especiales de Derprosa, con características diferenciadoras son el Anti-Fog Transparente y el Anti-Fog Anti-Bacteriano, con tratamiento antifog especial por una cara que evita la condensación y formación de vaho. Con film Anti-Fog de Derprosa los alimentos pueden ser conservados dentro de su envase en el frigorífico durante 15 días sin que se forme vaho en su interior, mientras que en un envase con film con barniz al segundo día de estar en el frigorífico ya ha formado vaho en su interior. Tanto el film Anti-Fog Transparente y como el Anti-Fog Anti-Bacteriano son imprimibles y pueden transformarse de inmediato sin tener que esperar a que se asienten sus propiedades, como ocurre con otros films similares, y además, el film Anti-Fog Anti-Bacteriano proporciona las características del film Anti-Bacteriano. Por sus cualidades, son films especialmente recomendados para el sector de frutas y hortalizas frescas semielaboradas, ensaladas preparadas y congelados.
Además de éstos, dentro de los films especiales de Derprosa para el sector de la alimentación, encontramos el film transparente low seal, el cavitado blanco low seal y el metalizado, utilizados principalmente en chocolates y helados, además del film transparente low seal termosellable a una cara e imprimible en la cara exterior, que se utiliza para las bolsistas para infusiones. En esta categoría también se encuentra el film transparente con piel de PE, utilizado en bollería, snacks y aperitivos.
Otra de las grandes innovaciones de Derprosa es el film Oxo-Biodegradable transparente, un film con la misma calidad que el resto de films de Derprosa que se degrada en un periodo entre 18 y 36 meses bajo ciertas condiciones de temperatura, luz y humedad. Éste film se emplea en aplicaciones especialmente respetuosas con el medioambiente.
Derprosa, además de la gama de films para food packaging que ofrece al mercado en la actualidad, brinda a sus clientes la oportunidad de desarrollar nuevos films a medida, a partir de volúmenes bajos, animándolos también a compartir sus necesidades o nuevas ideas con Derprosa y así poder ofrecerles desde la compañía nuevas soluciones para el sector de la alimentación.
About Us
Con presencia en más de 60 países en todo el mundo, Derprosa se ha convertido en una de las compañías de referencia en el mercado de la laminación, especializándose en la fabricación y comercialización de films especiales con recubrimiento.
Gracias a sus 25 años de experiencia en el sector y a su apuesta por la constante innovación, Derprosa ofrece una gran gama de films orientados a ofrecer las mejores soluciones adaptadas a la medida de cada producto.
Para más información prensa:
Vidal Berruga
vidal@advertty.com
www.derprosadeluxe.com
Sé el primero en comentar en «Derprosa ofrece una amplia gama de films para el sector de la alimentación»